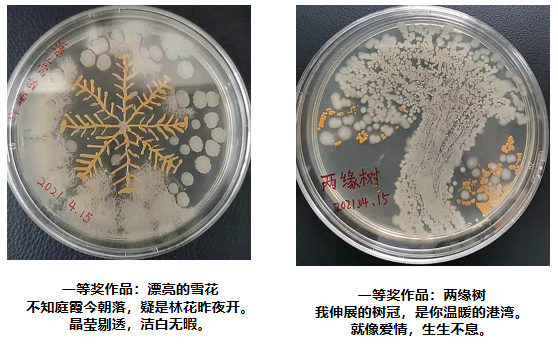
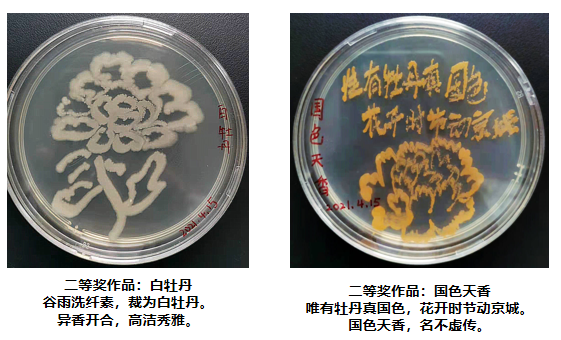

教师教学能力竞赛
医学院陈歌老师、张沂老师在2018年参加豫晋陕黄河金三角“超星杯”教师教学能力竞赛,分别获教学设计赛项二等奖、三等奖。



医学院王霖蕾、赵俊华和王芳参加2019年河南省高等卫生职业教育临床教师综合技能竞赛,成绩突出,分别荣获一等奖、二等奖、二等奖。







生理教学团队在洛阳职业技术学院第三届教学能力大赛中获得第二名

张明晓,河南省医学教育优质课教学评选中,荣获三等奖

2018年参加第二届全国职业院校临床医学专业临床技能大赛




2019年全国临床医学专业临床技能大赛
张彦芳院长和3名辅导教师选手比赛式合影
我校选手获奖照
全体辅导教师和选手比赛后总结会合影
三位获奖选手颁奖现场合影
三等奖获得者吴茜妍和辅导教师王冬晓
三等奖获得者韩若存和辅导教师王瑞丽
二等奖获得者田亚勤和辅导教师王芳
2020年11月参加鲁苏豫皖高等职业教育临床医学专业技能竞赛获奖情况

医学院学生参加2021年4月“河南省微生物学会第一届培养皿艺术大赛”

互联网+比赛
2019年河南省“互联网+”大学生创新创业大赛职教赛道比赛暨第五届中国“互联网+”大学生创新创业大赛职教赛道河南赛区选拔赛,获得二等奖

2020年“挑战杯”河南省大学生创业计划竞赛荣获银奖

薄俊辉,2018年6月,河南省经典照亮人生二等奖;

李春艳,2019年5月,河南省优秀应届生;

李俊才,2019年5月,河南省优秀应届生;

李世修2019年5月省级文明学生
张文杰2019年5月优秀青年志的
18级临床医学6班,2020年6月,河南省先进班集体;

代雪蕊,2020年6月,河南省三好学生;

尹苗苗,2020年6月,河南省优秀学生干部;

赵国源,2020年6月,河南省优秀学生干部;

2020年8月,洛阳市人才生涯规划大赛,赵文清三等奖才旺央措,优秀奖;周扬扬,优秀奖

“挑战杯”河南省大学生创业计划竞赛银奖

李梁,2021年1月河南省抗击新冠疫情肺炎青年志愿先进个人
崔锦,2021年3月,河南省百优魅力团支书

白坤,2021年5月,洛阳市优秀共青团员

2022年获奖情况
1.2022年4月“河南省高等职业院校技能大赛---中药传统技能”大赛,荣获1个二等奖和1个三等奖。
2.2022年5月中国病理生理学会“我与实验动物的故事”诗歌征文比赛,荣获1个最具人气作品,4个优秀作品。
3.2022年5月河南省高等职业教育教学能力大赛,荣获1个二等奖。
4.2022年5月河南省师德教育主题征文比赛,荣获1个二等奖。
5.2022年6月“活力杯”河南学校共青团基层基础工作大赛,荣获1个三等奖。
6.2022年6月河南省挑战杯创新创业大赛,荣获1个铜奖。
7.2022年6月洛阳职业技术学院课程思政教学创新大赛,荣获1个二等奖和2个三等奖。
8.2022年7月高等学校国家级实验教学示范中心联席会举办的第八届全国大学生基础医学创新研究暨实验设计论坛高职高专组比赛,荣获1个优秀奖。
9.2022年7月全国卫生职业教育解剖学专业研究会第十七届学术研讨会解剖绘图大奖赛,荣获1个一等奖,1个二等奖,3个三等奖。
10.2022年7月全国卫生职业教育解剖学专业研究会第十七届学术研讨会教学能力大奖赛,荣获1个一等奖,1个二等奖,2个三等奖。
11.2022年9月洛阳市科普讲解大赛,荣获1个优秀奖。
12.2022年9月河南省家政服务职业技能大赛洛阳选拔赛,2名教师获得入选省赛资格。







